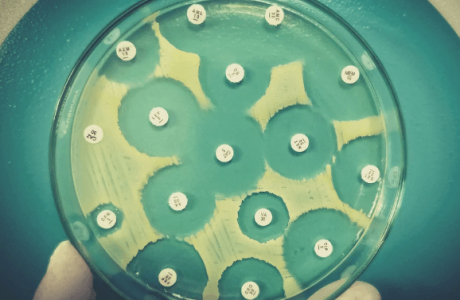
1676235300754.png 1676235300754.png

- 24 Апр 2020
- 7,314
- 14,727
-

- 6
Марихуана и антибиотики
В мире примерно несколько миллионов пользователей каннабиса, которые, как и мы с вами, иногда болеют. Однако не все болезни – это банальная простуда. Иногда мы сталкиваемся с более серьезными состояниями, для устранения которых требуется антибиотикотерапия.
Как быть в таких ситуациях? Можно ли использовать каннабис совместно с антибиотиками? Об этом и многом другом читайте в этой статье.
Бактерии и человек
Хочу сказать, что мы просто счастливчики, потому что нас угораздило родиться в эпоху науки и технологий! До изобретения антибиотиков люди на протяжении веков гибли сотнями от различных болезней, которые сейчас успешно лечатся при помощи нескольких таблеток.
Издавна микробы и бактерии считаются врагами человека. Стоит отметить, что не все. В нашем теле существуют целые колонии микроорганизмов, без которых, как бы странно это не звучало, нам пришлось бы туго. В нашем кишечнике находятся бактерии, которые помогают переваривать пищу и укрепляют нашу иммунную систему. Но не все виды бактерий хотят существовать с нами в симбиозе.
Существует бесконечное множество микроорганизмов, которые при воздействии на отдельные органы способны вызвать определенные болезни. Например, страшное заболевание с высокой вероятностью летального исхода – менингит, вызывают бактерии neisseria meningitidis (менингококк). Бактериальную ангину вызывает бета-гемолитический стрептококк группы А. А пневмонию – Streptococcus pneumoniae, Legionella pneumophila, Haemophilus influenzae, Neisseria meningitidis, Escherichia coli, Pseudomonas aeruginosa, Staphylococcus aureus, Acinetobacter baumannii, Klebsiella pneumoniae.
Эти бактерии могут передаваться различным путем. Через телесный контакт, пользование одними и теми же бытовыми приборами, воздушно-капельным путем и даже вместе с продуктами, не прошедшими термическую обработку. Бактериальная инфекция вещь совсем небезобидная. Если вовремя ее не лечить, все может закончиться плачевно. А лекарство одно – антибиотики. Они являются одним из важнейших открытий прошлого века!
Краткая история антибиотиков

Инфекционные заболевания всегда угрожали человечеству. Еще во времена древнего мира целители пытались бороться с множеством недугов при помощи плесени. Так, например, Ибн Сина, персидский врач, прикладывал повязки с зеленой плесенью на гноящиеся раны. Следы антибиотика тетрациклина были найдены в остатках тел человека в суданской Нубии, датируемой 350-550 годами нашей эры.
Однако должное стоит отдать Александру Флеменгу. Именно он в 1928 году обнаружил, что грибы Penicillium способны уничтожать бактерии стафилококков. Это произошло совершенно случайно, когда он вернулся с отпуска и увидел, что в чашке рядом с грибами не росли колонии этих микроорганизмов. Так он понял, что этот тип грибов вырабатывает некое вещество, которое убивает бактерии. Но, к сожалению, вывести это вещество в чистом виде он так и не смог. Спустя десять лет это сделали Г. Флори и Э. Чейн, за что в 1945 году получили Нобелевскую премию. Активное производство пенициллина началось в 1942 году, за счет чего удалось спасти миллионы жизней.
Как работают антибиотики?
Антибиотики работают двумя основными способами. Они либо помогают замедлить размножение вредных бактерий (бактериостатические), либо убивают их (бактерицидные).
Бактериостатические антибиотики не убивают полностью бактерии, а замедляют их рост. Таким образом они дают иммунной системе справиться с инфекцией самостоятельно. А делают они это путем вмешательства в репликацию ДНК, метаболизм и производство белка.
Бактерицидные антибиотики, как вы уже догадались, убивают сами бактерии. Все антибиотики пенициллинового ряда являются бактерицидными.
Антибиотики также различаются по видам бактерий, на которые они нацелены. Существуют антибиотики широкого спектра. Они уничтожают многие типы бактерий, включая «дружественные», которые находятся в кишечнике. Из-за этого могут начаться проблемы с пищеварением и развиться дисбактериоз.
Антибиотики узкого спектра поражают только один определенный вид бактерий, максимум два. Полезные бактерии остаются нетронутыми. Они продолжают дальше мирно существовать в нашем организме. Важно отметить, что антибиотики предназначены только для борьбы с бактериями. Они бесполезны при вирусных инфекциях. Потому что вирусы проникают в клетки-хозяева, которые антибиотики не атакуют. Они разрушают лишь клеточные стенки бактерий. Вирусы же не имеют стенок, поэтому антибиотикам и нечего разрушать.
Виды антибиотиков
- Цефалоспарины. Это антибиотики широкого спектра действия. Они используются для борьбы с многочисленными инфекциями. Их применяют для лечения менингита, пневмонии, септицемии;
- Аминогликозиды. Этот тип антибиотиков в основном используют в лечебных заведениях под присмотром врача, так как они имеют побочные действия. Чаще их применяют совместно с другими антибиотиками. Это препараты узкого спектра. Их действие направлено лишь на определенные типы грамотрицателтных бактерий;
- Тетрациклины. Антибиотики этого ряда убивают бактерии, разрушая синтез белка внутри них. К большому сожалению, в последнее время их эффективность снизилась, из-за устойчивости некоторых бактерий к антибиотикам этого вида. Тем не менее, их все еще используют для лечения акне;
- Макролиды. Их назначают пациентам с аллергией на пенициллин. Они эффективны при легочных инфекциях, в том числе и пневмонии;
- Фторхинолоны. В настоящее время их назначаются редко из-за частых побочных эффектов. Ранее антибиотиками этого типа лечили легочные инфекции и инфекции мочевыводящих путей.
Можно ли применять марихуану вместе с антибиотиками?
Все мы знаем, что антибиотики категорически не рекомендуется принимать совместно с алкоголем. А что насчет каннабиса?
Считается, что он имеет более безопасный профиль по сравнению со спиртным. Однако соединения, которые содержатся в марихуане, могут взаимодействовать с лекарственными препаратами. Наша печень как фильтрационный барьер, пропускает через себя все, что попадает в наш организм, в том числе и каннабиноиды. Семейство ферментов цитохрома Р450 метаболизирует некоторые каннабиноиды. Эти же ферменты расщепляют и 90% лекарственных препаратов. Из-за этого каннабиноиды усиливают или нейтрализуют действие некоторых лекарственных средств. Также они могут усиливать побочные реакции.
Как взаимодействует ТГК с антибиотиками?
ТГК взаимодействует с теми же ферментами печени, что и некоторые антибиотики. Поэтому потенциально существует риск возникновения побочных эффектов при совместном приеме марихуаны и антибиотиков. Хотя ни в одном из имеющихся исследований не описывается каких-либо серьезных последствий для здоровья человека от их одновременного применения каннабиса и антибактериальных препаратов.
С другой стороны, если у человека диагностирована легочная инфекция, применять каннабис не рекомендуется даже не из-за того, что он не сочетается с антибиотиками, а потому что он может усилить симптомы заболевания.
Мы не можем вам что-либо рекомендовать. Однако перед тем как применять каннабис, богатый на ТГК, вместе с лекарствами, подумайте хорошенько, а стоит ли оно того?
Как КБД взаимодействует с антибиотиками?
КБД действует как мощный ингибитор цитохрома Р450. Он может изменять метаболизм некоторых антибиотиков. Однако, как и в случае с ТГК, не существует подробных исследований, в которых бы описывались риски совместного приема обоих веществ. Поэтому все на свой страх и риск.
Может ли каннабис оказывать антибактериальное воздействие?

Как многие формы жизни на Земле, бактерии обладают способностью адаптироваться к угрозам. Эта черта позволила некоторым типам бактерий развить устойчивость к антибиотикам. Например, ранее золотистый стафилококк успешно лечился благодаря пенициллину или метициллину. Однако стафилококк мутировал, и теперь эти антибиотики считаются абсолютно бесполезными.
Всемирная организация здравоохранения рассматривает устойчивость бактерий к антибиотикам как одну из самых серьезных надвигающихся проблем для всего человечества. Первым делом, необходимо отказаться от бесконтрольного приема антибиотиков. Важно понимать, что эти препараты бесполезны при симптомах гриппа и простуды, даже если они продолжаются долгий период времени.
Антибиотики необходимо применять строго по назначению врача и только после установленной бактериальной инфекции. Некоторые врачи также любят назначать антибиотики направо и налево, так, для перестраховки. Делать этого нельзя.
Ну а наши дорогие ученые со своей стороны делают все возможное, чтобы найти новое эффективное средство, которое поможет бороться с бактериальными инфекциями. Так, например, исследователи тестируют ТГК и КБД на микробном поле. Ученые утверждают, что каннабидиол может избирательно убивать некоторые грамотрицательные бактерии, в том числе и возбудитель гонореи Neisseria gonorrhoeae.
Потенциал ТГК
Исследователи обратили внимание на каннабис, так как это растение производит достаточно большое количество терпенов и каннабиноидов. Было обнаружено, что эти соединения могут защищать само растения от поражения вредоносными микроорганизмами.
Первые исследования, датируемые 1976 годом, обнаружили бактериостатический и бактерицидный потенциал ТГК и КБД против грамположительных бактерий. Они также протестировали некоторые эфирные масла марихуаны, такие как пинен и лимонен. Исследования дали положительный результат. Ученые считают, что совместное сочетание каннабиноидов и терпенов может быть эффективным для лечения бактериальных инфекций. Но также они признают, что необходимы исследования на людях.
Другое исследование от 2008 года говорит, что этот каннабиноид продемонстрировал мощную активность против некоторых штаммов бактерий, устойчивых к метициллину.
Потенциал других каннабиноидов
Так как ТГК оказывает психотропное воздействие, вокруг этого вещества продолжаются нескончаемые споры. Ученые все же пытаются найти более безопасный вариант.
В центре внимания оказался другой каннабиноид – КБД. Он не вызывает опьянения и никак не влияет на когнитивные функции. К тому же, уже установлено, что каннабидиол обладает противовоспалительными и антиоксидантными свойствами. Его также проверили и проверяют на противомикробный потенциал.
Также изучался и каннабигерол (КБГ) на предмет антимикробного действия. Его сравнили с ванкомицином – лекарством, используемым для лечения многочисленных типов бактериальных инфекций.
Какой мы можем сделать вывод?
Как мы видим, у каннабиса есть весьма неплохой потенциал. Однако пока существуют только лишь доклинические исследования, поэтому вывод мы можем сделать один – этому миру срочно необходимы исследования на человеческих моделях, так как угроза антибиотикорезистентности растет с каждым днем. Остается пожелать ученым удачи.
Медицинские сорта конопли
Перед вами подборка из трех популярных медицинских сортов конопли с высоким уровнем содержания КБД и умеренным уровнем ТГК, которые пользуются особой популярностью в странах, где каннабис имеет легальный статус. Это проверенные временем растения, отличающиеся надежной генетической составляющей. Их довольно легко выращивать, что делает их подходящими для начинающих гроверов. Они приносят обильный урожай первоклассных шишек, способных помочь справиться с различными негативными симптомами многих заболеваний.
Сорт марихуаны Y Griega CBD от Medical Seeds

Урожайность: 500 г/м2; 400 г/куст
Период цветения: 63-70 дней
Содержание ТГК и КБД: Средний
Каннабиса Y Griega CBD – одно из самых популярных растений у медицинских пользователей и начинающих гроверов, которое комфортно себя чувствует в закрытом и открытом грунте. Его период цветения занимает 9-10 недель. Кусты обладают хорошей защитой от плесени, паразитов и грибков. Шишки дарят прекрасный аромат хвойного дерева и нежный вкус с нотками апельсина, лайма и лимона. Воздействие сопровождается легким энергетическим эффектом, который активно применяется при борьбе с глаукомой, артритом и депрессией. Тело получает приятную легкость, а сознание – ясность мыслей, что позволяет сосредоточиться на главном. Появляется хорошее настроение и позитивный эмоциональный настрой.
Y Griega CBD КУПИТЬ
Сорт конопли Cream Caramel CBD от Sweet Seeds

Урожайность: 400-550 г/м2; 375-600 г/куст
Период цветения: 56 дней
Содержание ТГК и КБД: 7-15% и 9-17%
Данный индика-сативный гибрид прекрасно подойдет тем гроверам, которые предпочитают сочетание приятных вкусоароматических качеств и легкость культивации. Растишка выделяется коренастым строением кустов, ветвистой структурой, коротким расстоянием между узлами роста, красивыми темно-зелеными листьями и крупными соцветиями. Его период цветения длится всего 8 недель. Воздействие сопровождается мягким лечебным расслаблением, которое устранять боль, пробуждает аппетит и помогает побороть бессонницу. Мысли приходят в порядок, а сознание устремляется в мир счастья и вдохновения.
Cream Caramel CBD КУПИТЬ
Сорт каннабиса DC Cure 1:1 Auto от Doctor's Choice

Урожайность: 50 г/м2; 50 г/куст
Жизненный цикл: 60-70 дней
Содержание ТГК и КБД: 6% и 6%
Прекрасное растение для тех гроверов, которые не любят слишком мощного и выбивающего из колеи воздействия. Его эффект может стать прекрасным лечебным средством для борьбы с болью, усталостью, депрессией, нервным напряжением и хронической бессонницей. Пользователя ждет приятное телесное расслабление и кристальная чистота сознания, которые позволяют насладиться каждой минутой свободного времени или с удовольствием заняться рутинной работой. Само растение проходит жизненный цикл за 60-70 дней. Рост зрелого куста составляет 50-120 см. Высокая стабильность, выносливость и неприхотливость помогут гроверу успешно провести культивацию без каких-либо проблем.
DC Cure 1:1 Auto КУПИТЬ
Последнее редактирование модератором:






















